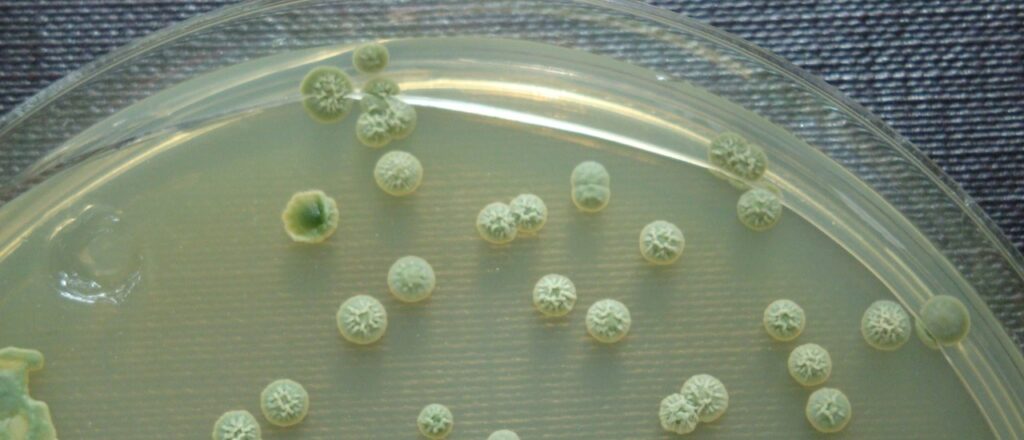

Las Brettanomyces son levaduras silvestres que pueden causar alteraciones en el vino generando un defecto organoléptico asociado a aromas negativos como “fenólico”, “establo” y “sudor de caballo”. Investigadores mendocinos han realizado numerosos estudios al respecto, y para transmitir estos conocimientos, el 15/5 a las 18.30 hs, la Academia Argentina de la Vid y el Vino (AAVV) invita a una charla dictada por la experta microbióloga del INTA EEA Mendoza, María Elena Sturm, moderada por Carlos Catania, autor del libro «Interpretación Sensorial del Vino» contenidos que actualmente se transmiten en el «Curso Superior de degustación de vinos». La actividad es gratuita pero con previa inscripción.

La contaminación del vino por levaduras indeseadas constituye un problema significativo para la industria vitivinícola, generando considerables pérdidas económicas. Entre ellas, Brettanomyces bruxellensis, la principal levadura que afecta a los vinos tintos, que se caracteriza por su crecimiento lento y alta tolerancia al etanol y suele manifestarse durante las etapas finales del proceso de vinificación y durante el envejecimiento en barrica. Es una levadura silvestre que puede causar alteraciones en el vino, su presencia puede generar olores desagradables a establo, cuero, sudor o heces, aunque también pueden producir aromas interesantes en algunas ocasiones.
Existen pocos estudios que aborden la diversidad de cepas presentes en las bodegas y su diseminación en éstas. Conocer la diversidad de cepas de estas poblaciones y su distribución en los diferentes vinos, puede contribuir a revelar el origen y momento de la contaminación, permitiendo el diseño de estrategias de prevención y control. Esto es muy importante porque los mercados mundiales exigen cada vez mayor calidad y productos libres de defectos.
Para conocer más sobre esta levadura, y aprender estrategias de prevención y control, la Academia Argentina de la Vid y el Vino invita a la charla «Brettanomyces ¿A qué nos enfrentamos?» una revisión de conceptos, dictada por la Dra. María Elena Sturm, microbióloga con un doctorado en Ciencias Biológicas, investigadora que trabaja en el área de microbiología enológica del INTA EEA Mendoza. Sturm ha participado en diversos proyectos e investigaciones referentes a la levadura Brettanomyces, entre ellos el reconocido y premiado desarrollo de «Microwine Predictor», una app que permite prevenir defectos en vinos y jugos de uva mediante modelos predictivos, aportando herramientas prácticas para el control de calidad.
La disertación estará moderada por el Ing. Carlos Catania, autor del libro «Interpretación Sensorial del Vino» que actualmente transmite en el «Curso Superior de degustación de vinos».
La actividad -gratuita pero con previa inscripción por cupos limitados- será el jueves 15 de mayo a las 18.30 hs, en el SUM del Instituto Nacional de Vitivinicultura (INV), Av. San Martín 430 de la ciudad de Mendoza (se ingresa por la playa de estacionamiento en calle Virgen del Carmen de Cuyo, disponible para los asistentes).
Reservar lugar al mail: secretaria.aavv@gmail.com